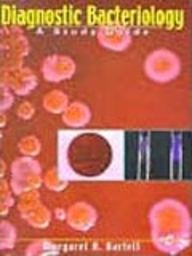
DIAGNOSTIC BACTERIOLOGY A STUDY GUIDE

DIAGNOSTIC BACTERIOLOGY A STUDY GUIDE
DIAGNOSTIC BACTERIOLOGY A STUDY GUIDE is backordered and will ship as soon as it is back in stock.
Couldn't load pickup availability
Genuine Products Guarantee
Genuine Products Guarantee
We guarantee 100% genuine products, and if proven otherwise, we will compensate you with 10 times the product's cost.
Delivery and Shipping
Delivery and Shipping
Products are generally ready for dispatch within 1 day and typically reach you in 3 to 5 days.
Author: Bartelt Margaret A
Brand: Jaypee Brothers Medical Publishers
Edition: 1/E
Binding: unknown_binding
Release Date: 01-12-2009
EAN: 9788184486650
Package Dimensions: 11.1 x 8.7 x 1.3 inches
Languages: English